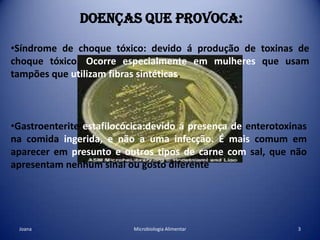
Doenças que provoca:Síndrome de choque tóxico: devido á produção de toxinas de choque tóxico. Ocorre especialmente em mulheres que usam tampões que utilizam fibras sintéticas.

Staphylococcus aureus é uma bactéria comum que vive na pele e nariz humanos e pode causar doenças como síndrome do choque tóxico, gastroenterite e impetigo. Ela causa infecções por meio de toxinas e pode infectar feridas, o sangue, ossos e pulmões, levando a problemas como osteomielite, endocardite e pneumonia. Os sintomas incluem febre, diarreia, dores no corpo e insuficiência de órgãos. O tratamento é feito com antibióticos comuns.